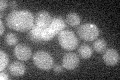
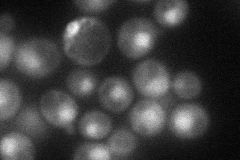
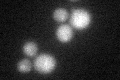
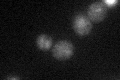

View description
Scaffold protein responsible for phagophore assembly site organization; regulatory subunit of an autophagy-specific complex that includes Atg1p and Atg13p; stimulates Atg1p kinase activity
Localization:
Intensity:
Fold change:
Significance:
-
C’ GFP library in SD
punctate17.89 -
N' NOP1pr-GFP in SD
cytosol,nucleus56.2587 -
N' TEF2pr-mCherry in SD

nucleus104.517 -
N' NATIVEpr-GFP in SD

punctate18.1224 -
N' TEF2pr-VC and Cyto-VN in SD

nucleus37.904 -
C’ GFP library in SD+DTT
punctate20.281.13No -
C’ GFP library in SD+H2O2

punctate19.621.09No -
C’ GFP library in Starvation Media
punctate21.141.18No -
C’ GFP library on the background of Pup2-DaMP

punctate -
C’ GFP library on the background of CCT mutant

punctate21.82311.21913No
